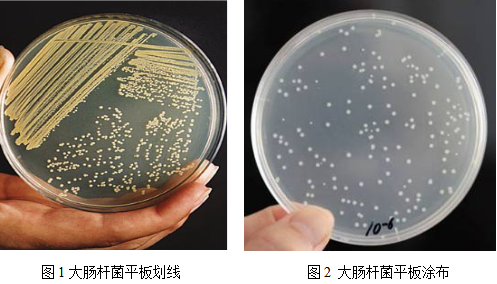

一、 实验原理
大肠杆菌是革兰氏阴性、兼性厌氧的肠道杆菌。微生物接种的方法有很多, 常用的是平板划线法和稀释涂布平板法。
平板划线法是通过接种环在琼脂固体培养基表面连续划线的操作,将聚集的菌种逐步稀释分散到培养基的表面。在数次划线后培养,可以分离到由一个细胞繁殖而来的肉眼可见的子细胞群体,这就是菌落。
稀释涂布平板法则是将菌液进行一系列的梯度稀释,然后将不同稀释度的菌液分别涂布到琼脂固体培养基的表面,进行培养。在稀释度足够高的菌液里,聚集在一起的微生物将被分散成单个细胞,从而能在培养基表面形成单个菌落。
二、实验目的
1、掌握用平板划线法分离纯化大肠杆菌的方法;
2、掌握用稀释涂布平板法分离纯化大肠杆菌的方法。
三、仪器与用具
高压灭菌锅,超净工作台,接种环,培养皿,酒精灯,试管,玻璃涂布器,pH试纸,微量可调移液器,恒温培养箱,大肠杆菌,微生物的实验室培养试剂盒。
四、试剂配制
培养基配制:倒取微生物试剂盒中的一瓶固体培养基33g加入800mL蒸馏水中,加热充分溶解(调节pH 6.8±2),定容至1000mL,分装至锥形瓶,牛皮纸或透气膜包扎瓶口,121℃高压灭菌20min,取出,冷却至60-70℃分装倒平板,每个平板约15-20mL,备用。
五、实验步骤
1、倒平板操作:
⑴将灭过菌的培养皿放在火焰旁的桌面上,右手拿装有培养基的锥形瓶,左手打开封口膜。
⑵右手拿锥形瓶,使瓶口迅速通过火焰。
⑶用左手的拇指和食指将培养皿打开一条稍大于瓶口的缝隙,右手将锥形瓶中的培养基(约18mL)倒入培养皿,左手立即盖上培养皿的皿盖。
⑷等待平板冷却凝固,大约需要5~10min。然后,将平板倒过来放置,使皿盖在下,皿底在上。
2、平板划线操作:
⑴将接种环放在火焰上灼烧,直到接种环烧红;
⑵在火焰旁冷却接种环,并打开试管冒;
⑶将试管口通过火焰;
⑷将已冷却的接种环深入菌液中,沾取一环菌液。
⑸将试管口通过火焰,并盖上试管冒。
⑹左手将皿盖打开一条缝隙,右手将沾有菌种的接种环迅速深入平板内,划三到五条平行线,盖上皿盖。注意不要划破培养基。
⑺灼烧接种环,待其冷却后,从 区域划线的末端开始往第二区域内划线。
重复以上操作,在三、四区域内划线。注意不要将 一区的划线与 区相连。
3、系列稀释操作:
⑴将分别盛有4.5mL水的5支试管灭菌,并按101~105的顺序编号。
⑵用移液管吸取0.5mL培养的菌液,注入第二支试管中。吹吸三次,使菌液与水充分混匀。
⑶从101倍稀释的试管中吸取0.5mL稀释液,注入102倍稀释的试管中,重复第2步的操作。依次类推,直到完成 一只试管的稀释。
4、涂布平板操作:
⑴用火焰灼烧涂布器灭菌,然后冷却8~10s。
⑵取少量菌液(0.1mL),滴加到培养基表面。
⑶用涂布器将菌液均匀地涂布在培养基表面。
六、实验结果与分析
如图1和2所示,大肠杆菌通过划线和平板稀释涂布的方法而分离, 终得到大肠杆菌的单菌落。
【注意事项】
1.实验操作过程中在无菌超净工作台中进行,严格控制无菌环境;
进行大肠杆菌平板划线分离培养时,1区到2区的划线,只能有一处引入,其他位置不可有所接触,同理,第4区位置不能与1区有接触。